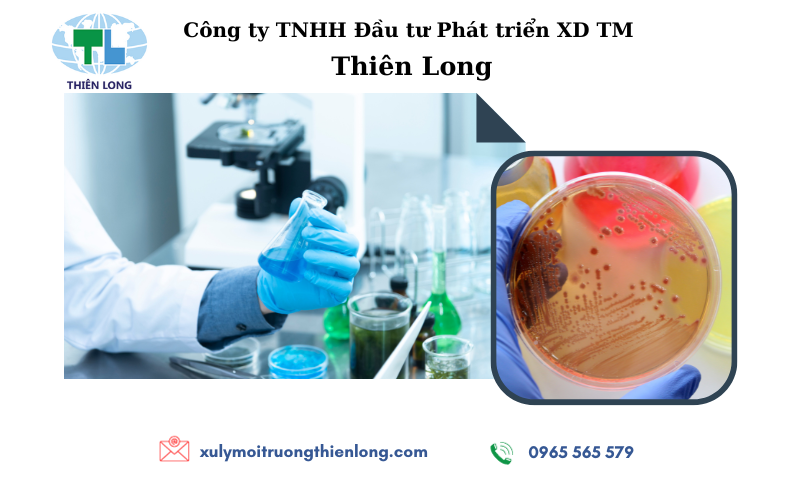

CÔNG NGHỆ XỬ LÝ KHÍ THẢI CHO XƯỞNG IN TỐT NHẤT HIỆN NAY
XỬ LÝ NƯỚC THẢI CHẾ BIẾN THỦY HẢI SẢN ĐẠT HIỆU QUẢ TỐT NHẤT
PHƯƠNG PHÁP XỬ LÝ BỤI XƯỞNG GỖ PHỔ BIẾN NHẤT
TOP 01 CÁCH XỬ LÝ NƯỚC THẢI SẢN XUẤT THUỐC BẢO VỆ THỰC VẬT HIỆU QUẢ NHẤT
CÔNG NGHỆ XỬ LÝ BỤI NHÀ MÁY SẢN XUẤT XI MĂNG TIÊN TIẾN
CÁCH ĐỂ XỬ LÝ NƯỚC THẢI CHỢ ĐƠN GIẢN NHẤT?
GIẢI PHÁP XỬ LÝ KHÍ THẢI NHÀ MÁY NHIỆT ĐIỆN
CÔNG NGHỆ XỬ LÝ NƯỚC THẢI KHU CÔNG NGHIỆP ĐƠN GIẢN NHẤT
XỬ LÝ KHÍ THẢI LÒ ĐỐT RÁC PHỔ BIẾN HIỆN NAY
TÍNH CHẤT VÀ PHƯƠNG PHÁP XỬ LÝ NƯỚC NHIỄM DẦU
GIẢI PHÁP XỬ LÝ KHÍ THẢI NHÀ MÁY TÁI CHẾ NHỰA AN TOÀN HIỆU QUẢ
TẠI SAO PHẢI XỬ LÝ NƯỚC THẢI CHĂN NUÔI HEO?
XỬ LÝ KHÍ THẢI LÒ HƠI ĐỐT THAN TỐI ƯU NHẤT
LÀM THẾ NÀO ĐỂ XỬ LÝ NƯỚC THẢI CHẾ BIẾN MỦ CAO SU HIỆU QUẢ NHẤT?
PHƯƠNG PHÁP XỬ LÝ KHÍ THẢI LÒ HƠI ĐỐT TRẤU HIỆU QUẢ NHẤT
CÔNG NGHỆ XỬ LÝ NƯỚC THẢI DỆT NHUỘM MỚI NHẤT
Các loại vi sinh trong xử lý nước thải
Vi sinh trong xử lý nước thảI
Vi sinh xử lý nước thảI là gì?
Vi sinh xử lý nước thảI là các loạI vi sinh vật có kích thước cực nhỏ, không thể nhìn được bằng mắt thường. Chúng có khả năng phân hủy các chất hữu cơ, vô cơ tồn tạI trong nước thảI để giúp cho nguồn nước đó trở nên trong sạch hơn.
Những loạI nấm men, nấm mốc, vi khuẩn, động vật nguyên sinh, giun, dòi,… là những vi sinh phổ biến. Trong đó vi khuẩn chiếm đến 90% trong số này. Chúng được chia thành nhiều loạI theo môi trường và cách thức mà chúng xử lý nước như vi sinh vật kỵ khí (yếm khí) và vi sinh hiếu khí trong xử lý nước thảI.
Quy trình xử lý nước thảI bằng vi sinh vật.
Công nghệ xử lý nước thảI bằng phương pháp sử dụng vi sinh vật dựa trên các hoạt động của chúng để phân hủy các chất hữu cơ gây ô nhiễm. Cụ thể, việc xử lý nước thảI bằng phương pháp vi sinh sử dụng sự phát triển để ăn các chất hữu cơ và khoáng chất. Quá trình này giúp phân hủy các chất độc trở thành các chất đơn giản hoắc thành khí và thoát ra ngoàI môi trường.
Vi sinh vật xử lý các chất hữu cơ gây hạI bằng cách tổng hợp thành chất nguyên sinh (tế bào) mớI. Quy trình xử lý nước thảI bằng vi sinh vật vận hành được thực hiện liên tục. Do đó, Vi sinh vật có thể hấp thụ một lượng lớn các chất hữu cơ qua bề mặt tế bào của chúng để tạo tế bào mớI.
Trong trường hợp phương pháp sinh học hiếu khí không thể hấp thụ các chất hữu cơ để đồng hóa thành tế bào chất mớI thì các chất hữu cơ này được oxy hóa để sản sinh ra năng lượng cần thiết cho việc tổng hợp.
Thời gian thích nghi và tăng trưởng của vi sinh cũng khác nhau, phụ thuộc vào các yếu tố :
· Dinh dưỡng có trong nước thải
· Thành phần và hàm lượng vi sinh vật cung cấp trong quá trình nuôi cấy
· Lưu lượng và nồng độ oxy cung cấp
· Các thành phần độc hại đến vi sinh có trong nước thải
· Nhiệt độ nước thải
· pH của nước thải
Trong quá trình nuôi cấy nếu kiểm soát được các yếu tố ở trên sẽ giúp quá trình nuôi cấy diễn ra thuận lợi, vi sinh vật dễ dàng phát triển và thích nghi.
Các loại vi sinh nuôi cấy có trên thị trường hiện nay
Bùn vi sinh
Bùn vi sinh là loại vi sinh thường được sử dụng trong quá trình nuôi cấy vi sinh. Bùn vi sinh ở dạng bùn lỏng gồm cả pha rắn kết hợp với nước.
Các vi sinh vật có lợi tồn tại trong bùn vi sinh sẽ tham gia vào quá trình phân hủy và chuyển hóa các chất hữu cơ có trong nước thải, làm sạch môi trường nước.
Tùy thuộc vào loại nước thải mà tính chất về màu sắc, kết cấu của bùn sẽ khác nhau.
· Bùn vi sinh hiếu khí: Có màu nâu nhạt, hơi sáng, ban đầu sẽ ở dạng lơ lửng nhưng khi bắt đầu lắng thì có hiện tượng tạo bông.
· Bùn vi sinh thiếu khí: Có màu nâu sẫm và hạt to hơn so với bùn vi sinh hiếu khí, tốc độ lắng của loại bùn này nhanh hơn bùn vi sinh hiếu khí.
· Bùn vi sinh kỵ khí: Có màu đen, được chia thành bùn lơ lửng và bùn hạt. Bùn hạt tạo bông to, lắng nhanh, bùn hạt càng lớn thì vi sinh vật bên trong phát triển càng tốt.

Ưu điểm
✔ Phân hủy hiệu quả các chất hữu cơ trong nước thảI, giúp loạI bỏ BOD, N, P.
✔ Quá trình xử lý diễn ra tự nhiên nhờ hoạt động của vi sinh vật, thân thiện vớI môi trường.
✔ Chi phí đầu tư và vận hành thấp do không cần sử dụng hóa chất.
✔ Công nghệ đơn giản, dễ vận hành và bảo trì.
✔ Có thể xử lý được các loạI nước thảI khác nhau như sinh hoạt, công nghiệp.
✔ Tạo ra lượng bùn thảI Ít hơn so vớI các công nghệ khác.
Nhược điểm
✘ Yêu cầu oxy hòa tan cao để duy trì hoạt động của vi sinh vật.
✘ Cần bổ sung chất dinh dưỡng định kỳ để duy trì hoạt tính của bùn.
✘Quá trình xử lý chậm hơn so vớI phương pháp hóa lý.
✘ĐòI hỏI hệ thống kỹ thuật phức tạp để vận hành ổn định.
✘Dễ bị ảnh hưởng bởI nhiệt độ và độ pH của môi trường.
Vi sinh dạng lỏng
Là loại vi sinh nhân tạo được tổng hợp từ các nguồn vi sinh khác nhau ở dạng lỏng, do vậy vi sinh thường đậm đặc ở chế độ chờ kích hoạt.
Trung bình mỗi ml chứa khoảng 3×10^7 CFU/mL.

Ưu điểm
✔Có nhiều loại vi sinh khác nhau, mỗi loại sẽ phù hợp với các loại nước thải khác nhau.
✔Vận chuyển và bảo quản dễ dàng do vi sinh dạng đặc, chiếm ít thể tích và khối lượng.
✔Khi đưa vào hệ thống xử lý nước thải men vi sinh dạng lỏng, khả năng sống của các chủng vi sinh vật có thể đạt đến 99%.
✔Sử dụng, vận hành đơn giản.
Nhược điểm
✘Giá thành cao
✘Tốn thời gian kích hoạt và thích nghi với nước thải (khoảng 30 phút).
✘Bảo quản khắt khe (từ 10 - 40°C), HSD ngắn (2 năm)
Ứng dụng
Dùng khử mùi tại các bãi rác, chuồng trại. Vì đặc tính dễ thẩm thấu và phun xịt trên diện rộng nên vi sinh dạng nước sẽ phù hợp dùng ở những nơi bề mặt có nhiều vật thể như chuồng trại, bãi rác.
Vi sinh dạng bột
Vi sinh tồn tại dưới dạng bột rắn, chứa nhiều chủng vi sinh khác nhau ở chế độ chờ kích hoạt.
Trung bình mỗi gram chứa khoảng 5×10^9 CFU/mL.

Ưu điểm
✔Vận chuyển và bảo quản dễ dàng do vi sinh dạng bột, khối lượng nhẹ
✔Có nhiều loại vi sinh khác nhau, mỗi loại sẽ phù hợp với các loại nước thải khác nhau.
✔Khi đưa vào hệ thống xử lý nước thải men vi sinh dạng lỏng, khả năng sống của các chủng vi sinh vật là 80%.
Nhược điểm
✘Tốn thời gian kích hoạt và thích nghi với nước thải.
✘Giá thành thấp hơn dạng lỏng
Ứng dụng
Với mật độ vi sinh cao, dạng bột phù hợp để xử lý trực tiếp các chất thải khó phân hủy như tinh bột, ủ phân, chất rắn lơ lửng trong nước thải, càng nhiều vi sinh, tốc độ xử lý càng nhanh.
Dịch vụ xử lý vấn đề môi trường tại – Công ty TNHH Đầu Tư Phát triển TM XD Thiên Long
Với phương châm “Uy tín tạo nên chất lượng” mỗi sản phẩm, mỗi dự án lắp đặt cho khách hàng đều được Thiên Long thực hiện bằng cả tâm huyết. Chúng tôi cam kết tất cả sản phẩm Thiên Long được làm từ nguyên liệu chất lượng, ứng dụng công nghệ và giải pháp tiên tiến nhất hiện nay. Khách hàng mang đến Thiên Long bài toán môi trường của mình, Thiên Long gửi lại lời giải tiết kiệm và tối ưu nhất cho khách hàng.
Qúy doanh nghiệp có nhu cầu hợp tác công ty để thi công lắp đặt hệ thống xử lý vấn đề môi trường hoặc quan tâm đến các hạng mục khác, hãy liên hệ với chúng tôi qua HOTLINE: 0965 565 579





















Vui lòng thực hiện các vấn đề dưới đây: